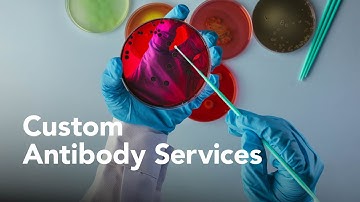
R&D Systems Custom Antibody Generation Services - Bio-Techne

⬇ DOWNLOAD NOW
Kalau muncul iklan pop-up, tutup lalu klik tombol kembali
Download lagu R&D Systems Custom Protein Development Services - Bio-Techne secara gratis hanya untuk keperluan promosi. Dukung artis favorit kamu dengan membeli musik original di iTunes atau platform resmi lainnya.
 R&D Systems Custom Reagents & Contract Services - Bio-Techne
R&D Systems Custom Reagents & Contract Services - Bio-Techne
R&D Systems Custom Antibody Generation Services - Bio-Techne
R&D Systems Custom Antibody Generation Services - Bio-Techne
 R&D Systems Custom Recombinant Antibody Services - Bio-Techne
R&D Systems Custom Recombinant Antibody Services - Bio-Techne
 Martin Ramsden from Bio-Techne talks Commercial Development
Martin Ramsden from Bio-Techne talks Commercial Development
 R&D Systems Biotinylated Proteins
R&D Systems Biotinylated Proteins
 R&D Systems Luminex Custom Services - Multiplexing with Bio-Techne
R&D Systems Luminex Custom Services - Multiplexing with Bio-Techne
 R&D Systems Fluorescent Labeled Proteins for CAR Research
R&D Systems Fluorescent Labeled Proteins for CAR Research
 R&D Systems Biomarker Sample Testing Services - Bio-Techne
R&D Systems Biomarker Sample Testing Services - Bio-Techne